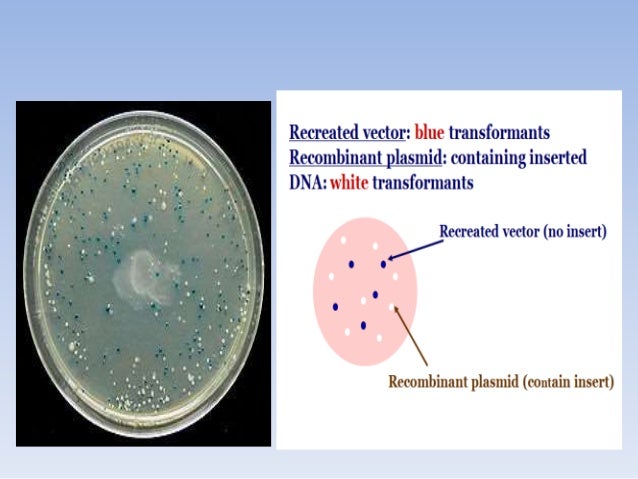
Plant transformation vectors and their types

← types of viral vectors Topical viral vectors for transfer of genes to the skin types of vectors with definition Physics for kids: basic vector math →
If you are searching about Final+ppt+viral+vectors+ you've visit to the right web. We have 35 Pictures about Final+ppt+viral+vectors+ like Topical Viral Vectors for Transfer of Genes to the Skin - Regrowth, Innovative Epilepsy Therapies for the 21st Century - Part 3 and also Plant Viral Vectors for Delivery by Agrobacterium | SpringerLink. Here you go:
Final+ppt+viral+vectors+
 www.slideshare.net
www.slideshare.net
List Of Insect Vector Transmitted Plant Diseases & Terminology
 www.slideshare.net
www.slideshare.net
transmitted terminology
Vectors
 www.slideshare.net
www.slideshare.net
Topical Viral Vectors For Transfer Of Genes To The Skin - Regrowth
 www.regrowth.com
www.regrowth.com
viral vectors genes vaccine transfer ppt presentation regrowth poor powerpoint development skip
Plant Transformation Vectors And Their Types
 www.slideshare.net
www.slideshare.net
Transgenic Plants Ppt
 www.slideshare.net
www.slideshare.net
transgenic
Final+ppt+viral+vectors+
 www.slideshare.net
www.slideshare.net
Viral Vectors, Non-Viral Vectors And Gene Therapy Manufacturing Market
viral non vectors vector gene therapy insights example
Viral Vectors In Virology
 www.slideshare.net
www.slideshare.net
viral vectors virology slideshare
Plant Transformation Vectors And Their Types
 www.slideshare.net
www.slideshare.net
transformation
Comparing Viral Vector Expression Systems - Bitesize Bio
 bitesizebio.com
bitesizebio.com
viral expression vector table comparing systems vectors cloning advantages considerations below applications bitesizebio lt
Manufacturing Of Viral Vectors - Bioprocess Development Forum
 www.processdevelopmentforum.com
www.processdevelopmentforum.com
viral vectors vector manufacturing development
Insect Vector Of Plant Viral Diseases
 www.slideshare.net
www.slideshare.net
diseases plant insect viral vector slideshare
The Ultimate Review On How Biotech Changed Cancer
 www.labiotech.eu
www.labiotech.eu
biotech nbt 1769 plasmid
Molecular Plant Pathology : Plant Virus Based Vectors
 www.ars.usda.gov
www.ars.usda.gov
plant virus vectors based viral diseases poultry newcastle disease such animal
Final+ppt+viral+vectors+
 www.slideshare.net
www.slideshare.net
PLANT VIRUS PPT - SLIDE SHARE
 www.slideshare.net
www.slideshare.net
plant virus viruses ppt botany notes subject slideshare introduction examination exam slide
Virus: Virus Structure, Plant Viral Diseases, Animal Viral Diseases
 www.gktoday.in
www.gktoday.in
virus plant structure viral diseases types animal gktoday
Plant Viral Vectors For Delivery By Agrobacterium | SpringerLink
 link.springer.com
link.springer.com
agrobacterium viral vectors delivery plant fig
Emerging Platform Bioprocesses For Viral Vectors And Gene Therapies
 bioprocessintl.com
bioprocessintl.com
process viral gene vectors manufacturing therapies vector typical emerging bioprocesses bioprocess platform overview word figure
Emerging Platform Bioprocesses For Viral Vectors And Gene Therapies
 www.bioprocessintl.com
www.bioprocessintl.com
viral vectors gene table overview bioprocesses therapies emerging platform bioprocessintl
Final+ppt+viral+vectors+
 www.slideshare.net
www.slideshare.net
viral
Potato Virus X Vector-mediated DNA-free Genome Editing In Plants
 www.naro.affrc.go.jp
www.naro.affrc.go.jp
plant virus genome vector editing topics viral plants method dna potato mediated fig
10 Examples Of Viral Diseases Of Plants
 www.examplesof.net
www.examplesof.net
diseases viral plants examples plant control symptoms leaf credit
[PDF] Plant Viral Vectors As A Tool For Recombinant Vaccine Production
![[PDF] Plant Viral Vectors as a Tool for Recombinant Vaccine Production](https://d3i71xaburhd42.cloudfront.net/a5fb5d9769719f72c69a2e7540fb93b6ff7b5f4c/5-Figure3-1.png) www.semanticscholar.org
www.semanticscholar.org
figure recombinant viral tool vectors plant vaccine production
[PDF] Plant Viral Vectors As A Tool For Recombinant Vaccine Production
![[PDF] Plant Viral Vectors as a Tool for Recombinant Vaccine Production](https://d3i71xaburhd42.cloudfront.net/a5fb5d9769719f72c69a2e7540fb93b6ff7b5f4c/3-Figure1-1.png) www.semanticscholar.org
www.semanticscholar.org
viral plant vectors figure recombinant tool vaccine production
Frontiers | Viral Vectors For Plant Genome Engineering | Plant Science
 journal.frontiersin.org
journal.frontiersin.org
plant genome engineering viral vectors geminivirus frontiersin mechanism mediated figure fpls
Viral Vectors, Non-Viral Vectors And Gene Therapy Manufacturing Market
gene therapy market vectors viral vector manufacturing aav dna plasmid
Insect Vector Of Plant Viral Diseases
 www.slideshare.net
www.slideshare.net
diseases
Pin On Social Media Calendar
 www.pinterest.com
www.pinterest.com
Frontiers | Viral Vectors For Plant Genome Engineering | Plant Science
 www.frontiersin.org
www.frontiersin.org
plant viral genome engineering vectors frontiersin important table fpls
German Gene Therapy Biotech Breakthrough In Viral Vectors
 labiotech.eu
labiotech.eu
gene therapy viral vector vectors aav types biotech production german adenoviral lentiviral rca getdrawings commonly breakdown fig which most
Viral Vectors In Virology
 www.slideshare.net
www.slideshare.net
virology
Plant Transformation Vectors And Their Types
www.slideshare.net
www.slideshare.net
Innovative Epilepsy Therapies For The 21st Century - Part 3
 www.medscape.org
www.medscape.org
slide vectors viral types
Plant transformation vectors and their types. Viral vectors gene table overview bioprocesses therapies emerging platform bioprocessintl. Plant virus genome vector editing topics viral plants method dna potato mediated fig
